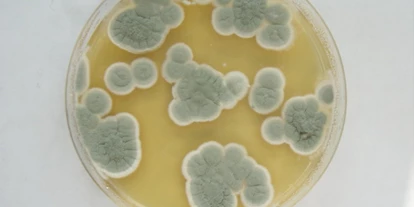
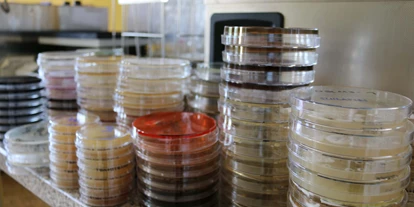

86 Unternehmen mit bevorzugter Kontakt: per Telefon gefunden (von 238)
-
Standard Sortierung erklärt
Die Sortierung erfolgt nach der Anzahl von Punkten, die ein Unternehmen-Eintrag gesammelt hat (0 bis 200 Punkte).
Punkte erhält ein Eintrag für Vollständigkeit (ausgefüllte Eigenschaften und Bilder) und Bewertungen.
In Kombination mit der Freitextsuche zeigen wir vorrangig zum Suchbegriff passende Unternehmen.
-
Treppenlifte, Plattformlifte, Hublifte
14532 Stahnsdorf, Brandenburg, Deutschland
Art des Unternehmens:Sonstige DienstleistungenSonstige DienstleistungenGutscheinkauf möglich133Daten werden geladen...
zu Favoritenliste hinzugefügt
Favoritenliste anzeigenaus Favoritenliste entfernt
Favoritenliste anzeigen -
Kleidung, Accessoires, Taschen
10781 Berlin, Berlin, Deutschland
Art des Unternehmens:Modegeschäft Schmuck TextilprodukteModegeschäftSchmuckTextilprodukteGutscheinkauf möglich130Daten werden geladen...
zu Favoritenliste hinzugefügt
Favoritenliste anzeigenaus Favoritenliste entfernt
Favoritenliste anzeigen -
Barf Hundefutter Katzenfutter Training Pferdezusatz
36041 Fulda, Hessen, Deutschland
Art des Unternehmens:TierbedarfTierbedarfGutscheinkauf möglich117Daten werden geladen...
zu Favoritenliste hinzugefügt
Favoritenliste anzeigenaus Favoritenliste entfernt
Favoritenliste anzeigen -
10437 Berlin, Berlin, Deutschland
Art des Unternehmens:LebensmittelladenLebensmittelladenGutscheinkauf möglich113Daten werden geladen...
zu Favoritenliste hinzugefügt
Favoritenliste anzeigenaus Favoritenliste entfernt
Favoritenliste anzeigen -
Bücher, Zeitschriften, Papeterie, Spiele, Spielzeug, Comics, Spielwaren
10405 Berlin, Berlin, Deutschland
Art des Unternehmens:Bastelladen Bücherei LieferungenBastelladenBüchereiLieferungenSpielwarengeschäftGutscheinkauf möglich105Daten werden geladen...
zu Favoritenliste hinzugefügt
Favoritenliste anzeigenaus Favoritenliste entfernt
Favoritenliste anzeigen -
Fotostudio, Pass, Bewerbung, Hochzeit, Portraits, Fotobox-Verleih, Fotogeschäft
36041 Fulda, Hessen, Deutschland
Art des Unternehmens:Elektronik Lernen / Coaching LieferungenElektronikLernen / CoachingLieferungenSonstige DienstleistungenGutscheinkauf möglich105Daten werden geladen...
zu Favoritenliste hinzugefügt
Favoritenliste anzeigenaus Favoritenliste entfernt
Favoritenliste anzeigen -
Maßhemden online made in EU
69251 Gaiberg, Baden-Württemberg, Deutschland
Art des Unternehmens:Modegeschäft Lieferungen SchneidereiModegeschäftLieferungenSchneidereiSonstige DienstleistungenTextilprodukteGutscheinkauf möglich105Daten werden geladen...
zu Favoritenliste hinzugefügt
Favoritenliste anzeigenaus Favoritenliste entfernt
Favoritenliste anzeigen -
Business.Data.Experts.
10178 Berlin, Berlin, Deutschland
Art des Unternehmens:IT Dienstleistungen Rohstoffe Sonstige DienstleistungenIT DienstleistungenRohstoffeSonstige Dienstleistungen105Daten werden geladen...
zu Favoritenliste hinzugefügt
Favoritenliste anzeigenaus Favoritenliste entfernt
Favoritenliste anzeigen -
Uhren und Schmuck Juwelier mit Uhrmachermeisterwerkstatt in 89584 Ehingen
89584 Ehingen (Donau), Baden-Württemberg, Deutschland
Art des Unternehmens:Schmuck Sonstige DienstleistungenSchmuckSonstige DienstleistungenGutscheinkauf möglich104Daten werden geladen...
zu Favoritenliste hinzugefügt
Favoritenliste anzeigenaus Favoritenliste entfernt
Favoritenliste anzeigen -
Ihre Boutique am Marktplatz, Damen- & Herrenmode, Accessoires, Taschen, Schmuck
15806 Zossen, Brandenburg, Deutschland
Art des Unternehmens:Modegeschäft Schmuck TextilprodukteModegeschäftSchmuckTextilprodukteGutscheinkauf möglich102Daten werden geladen...
zu Favoritenliste hinzugefügt
Favoritenliste anzeigenaus Favoritenliste entfernt
Favoritenliste anzeigen -
Ihre Boutique am Marktplatz, Damenmode, Accessoires, Taschen, Schmuck
14959 Trebbin, Brandenburg, Deutschland
Art des Unternehmens:Modegeschäft Schmuck TextilprodukteModegeschäftSchmuckTextilprodukteGutscheinkauf möglich102Daten werden geladen...
zu Favoritenliste hinzugefügt
Favoritenliste anzeigenaus Favoritenliste entfernt
Favoritenliste anzeigen -
Tragbare Kunst in limitieren Kleinauflagen oder als Unikat gefertigt.
20459 Hamburg, Hamburg, Deutschland
Art des Unternehmens:Dekoration Modegeschäft Schuhe & LederwarenDekorationModegeschäftSchuhe & LederwarenTextilprodukteGutscheinkauf möglich101Daten werden geladen...
zu Favoritenliste hinzugefügt
Favoritenliste anzeigenaus Favoritenliste entfernt
Favoritenliste anzeigen -
Die Sonne des Südens trifft auf die Produkte des Nordens.
23552 Lübeck, Schleswig-Holstein, Deutschland
Art des Unternehmens:Catering Lebensmittelladen LieferungenCateringLebensmittelladenLieferungenRestaurantGutscheinkauf möglich101Daten werden geladen...
zu Favoritenliste hinzugefügt
Favoritenliste anzeigenaus Favoritenliste entfernt
Favoritenliste anzeigen -
"Kunst zu bezahlbaren Preisen"
01099 Dresden, Sachsen, Deutschland
Art des Unternehmens:Büroausstattung Lernen / Coaching Sonstige DienstleistungenBüroausstattungLernen / CoachingSonstige DienstleistungenGutscheinkauf möglich99Daten werden geladen...
zu Favoritenliste hinzugefügt
Favoritenliste anzeigenaus Favoritenliste entfernt
Favoritenliste anzeigen -
24558 Henstedt-Ulzburg, Schleswig-Holstein, Deutschland
Art des Unternehmens:Sonstige DienstleistungenSonstige Dienstleistungen94Daten werden geladen...
zu Favoritenliste hinzugefügt
Favoritenliste anzeigenaus Favoritenliste entfernt
Favoritenliste anzeigen -
Hygiene ist unsere tägliche Arbeit.
02977 Hoyerswerda, Sachsen, Deutschland
Art des Unternehmens:Lernen / Coaching Sonstige DienstleistungenLernen / CoachingSonstige DienstleistungenGutscheinkauf möglich93Daten werden geladen...
zu Favoritenliste hinzugefügt
Favoritenliste anzeigenaus Favoritenliste entfernt
Favoritenliste anzeigen -
Videoproduktion
08107 Kirchberg, Sachsen, Deutschland
Art des Unternehmens:Sonstige DienstleistungenSonstige DienstleistungenGutscheinkauf möglich93Daten werden geladen...
zu Favoritenliste hinzugefügt
Favoritenliste anzeigenaus Favoritenliste entfernt
Favoritenliste anzeigen -
Auto verkaufen in Rottweil: Ihr Partner für Gebrauchtwagenankauf
78628 Rottweil, Baden-Württemberg, Deutschland
Art des Unternehmens:KFZ-ZubehörKFZ-ZubehörGutscheinkauf möglich92Daten werden geladen...
zu Favoritenliste hinzugefügt
Favoritenliste anzeigenaus Favoritenliste entfernt
Favoritenliste anzeigen -
Autoankauf Kaufbeuren – schnell verkauft, fair bezahlt.
87600 Kaufbeuren, Nordrhein-Westfalen, Deutschland
Art des Unternehmens:KFZ-ZubehörKFZ-ZubehörGutscheinkauf möglich92Daten werden geladen...
zu Favoritenliste hinzugefügt
Favoritenliste anzeigenaus Favoritenliste entfernt
Favoritenliste anzeigen -
In Heidenheim an der Brenz gibt es zahlreiche Möglichkeiten, ein Auto zu kaufen
89518 Heidenheim an der Brenz, Baden-Württemberg, Deutschland
Art des Unternehmens:KFZ-ZubehörKFZ-ZubehörGutscheinkauf möglich92Daten werden geladen...
zu Favoritenliste hinzugefügt
Favoritenliste anzeigenaus Favoritenliste entfernt
Favoritenliste anzeigen -
Autoankauf Brühl – Schnell verkaufen, fair profitieren!“
50321 Brühl, Nordrhein-Westfalen, Deutschland
Art des Unternehmens:KFZ-ZubehörKFZ-ZubehörGutscheinkauf möglich92Daten werden geladen...
zu Favoritenliste hinzugefügt
Favoritenliste anzeigenaus Favoritenliste entfernt
Favoritenliste anzeigen -
Mode erleben
29221 Celle, Niedersachsen, Deutschland
Art des Unternehmens:ModegeschäftModegeschäftGutscheinkauf möglich91Daten werden geladen...
zu Favoritenliste hinzugefügt
Favoritenliste anzeigenaus Favoritenliste entfernt
Favoritenliste anzeigen -
Ihr Körper ist Ihr wertvollster Besitz. Pflegen Sie ihn mit wertvollen Produkte.
09120 Chemnitz - Bernsdorf
Art des Unternehmens:Körperpflege & KosmetikKörperpflege & KosmetikGutscheinkauf möglich91Daten werden geladen...
zu Favoritenliste hinzugefügt
Favoritenliste anzeigenaus Favoritenliste entfernt
Favoritenliste anzeigen -
It is all about You.
81925 München, Bayern, Deutschland
Art des Unternehmens:SportgeschäftSportgeschäftGutscheinkauf möglich90Daten werden geladen...
zu Favoritenliste hinzugefügt
Favoritenliste anzeigenaus Favoritenliste entfernt
Favoritenliste anzeigen
Interessante Unternehmen
-
 Kikobell Lieblingsmode in Trebbin
Kikobell Lieblingsmode in Trebbin
Ihre Boutique am Marktplatz, Damenmode, Accessoires, Taschen, Schmuck
Trebbin -
 Labor für Mikrobiologie und Hygiene
Labor für Mikrobiologie und Hygiene
Hygiene ist unsere tägliche Arbeit.
Hoyerswerda -
 Funkenzauber Feuerwerke
Funkenzauber Feuerwerke
Hochzeitsfeuerwerk, Geburtstagsfeuerwerk, Firmenfeuerwerk, Feuerwerk
Langenhagen -
 camarocaro - Caroline Körner
camarocaro - Caroline Körner
Geschenke Onlineshop für Tierfreunde
Markneukirchen -
 Allround Fliesenleger - Badsanierung und Komplettsanierung
Henstedt-Ulzburg
Allround Fliesenleger - Badsanierung und Komplettsanierung
Henstedt-Ulzburg
-
 Fine Cotton Company
Fine Cotton Company
Maßhemden online made in EU
Gaiberg

.png)